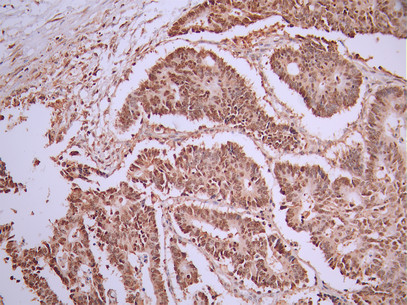

-
中文名稱:PSIP1 Recombinant Monoclonal Antibody
-
貨號:CSB-RA275990A0HU
-
規格:¥1320
-
圖片:
-
Western Blot
Positive WB detected in: HepG2 whole cell lysate(30μg), Jurkat whole cell lysate(30μg), Hela whole cell lysate(30μg)
All lanes: PSIP1 antibody at 1:1000
Secondary
Goat polyclonal to rabbit IgG at 1/40000 dilution
Predicted band size: 60 kDa
Observed band size: 75 kDa
Exposure time:1min -
IHC image of CSB-RA275990A0HU diluted at 1:100 and staining in paraffin-embedded human spleen tissue performed on a Leica BondTM system. After dewaxing and hydration, antigen retrieval was mediated by high pressure in a citrate buffer (pH 6.0). Section was blocked with 10% normal goat serum 30min at RT. Then primary antibody (1% BSA) was incubated at 4°C overnight. The primary is detected by a Goat anti-rabbit polymer IgG labeled by HRP and visualized using 0.05% DAB.
-
IHC image of CSB-RA275990A0HU diluted at 1:100 and staining in paraffin-embedded human colorectal cancer performed on a Leica BondTM system. After dewaxing and hydration, antigen retrieval was mediated by high pressure in a citrate buffer (pH 6.0). Section was blocked with 10% normal goat serum 30min at RT. Then primary antibody (1% BSA) was incubated at 4°C overnight. The primary is detected by a Goat anti-rabbit polymer IgG labeled by HRP and visualized using 0.05% DAB.
-
Overlay Peak curve showing SH-SY5Y cells stained with CSB-RA275990A0HU (red line) at 1:100. The cells were fixed in 4% formaldehyde and permeated by 0.2% TritonX-100 for 10min. Then 10% normal goat serum to block non-specific protein-protein interactions followed by the antibody (1ug/1*106cells) for 45min at 4℃. The secondary antibody used was FITC-conjugated goat anti-rabbit IgG (H+L) at 1/200 dilution for 35min at 4℃.Control antibody (green line) was Rabbit IgG (1ug/1*106cells) used under the same conditions. Acquisition of >10, 000 events was performed.
-
-
其他:
產品詳情
-
Uniprot No.:
-
基因名:
-
別名:CLL associated antigen KW 7; CLL-associated antigen KW-7; Dense fine speckles 70 kDa protein; DFS 70; DFS70; LEDGF; Lens epithelium derived growth factor; Lens epithelium-derived growth factor; MGC74712; p52; p75; PAIP; PC4 and SFRS1 interacting protein 1; PC4 and SFRS1 interacting protein 2; PC4 and SFRS1 interacting protein; PC4 and SFRS1-interacting protein; PSIP 1; PSIP 2; Psip1; PSIP1_HUMAN; PSIP2; Transcriptional coactivator p75/p52
-
反應種屬:Human
-
免疫原:A synthesized peptide from human PSIP1 protein
-
免疫原種屬:Homo sapiens (Human)
-
標記方式:Non-conjugated
-
克隆類型:Monoclonal
-
抗體亞型:Rabbit IgG
-
純化方式:Affinity-chromatography
-
克隆號:5H8
-
濃度:It differs from different batches. Please contact us to confirm it.
-
保存緩沖液:Rabbit IgG in 10mM phosphate buffered saline , pH 7.4, 150mM sodium chloride, 0.05% BSA, 0.02% sodium azide and 50% glycerol.
-
產品提供形式:Liquid
-
應用范圍:ELISA, WB, IHC, FC
-
推薦稀釋比:
Application Recommended Dilution WB 1:500-1:5000 IHC 1:50-1:200 FC 1:50-1:200 -
Protocols:
-
儲存條件:Upon receipt, store at -20°C or -80°C. Avoid repeated freeze.
-
貨期:Basically, we can dispatch the products out in 1-3 working days after receiving your orders. Delivery time maybe differs from different purchasing way or location, please kindly consult your local distributors for specific delivery time.
-
用途:For Research Use Only. Not for use in diagnostic or therapeutic procedures.
相關產品
靶點詳情
-
功能:Transcriptional coactivator involved in neuroepithelial stem cell differentiation and neurogenesis. Involved in particular in lens epithelial cell gene regulation and stress responses. May play an important role in lens epithelial to fiber cell terminal differentiation. May play a protective role during stress-induced apoptosis. Isoform 2 is a more general and stronger transcriptional coactivator. Isoform 2 may also act as an adapter to coordinate pre-mRNA splicing. Cellular cofactor for lentiviral integration.
-
基因功能參考文獻:
- structurally conserved IBD-binding motifs (IBMs) on known LEDGF/p75 binding partners can be regulated by phosphorylation, permitting switching between low- and high-affinity states. PMID: 29997176
- findings suggest a novel role of LEDGF/p75 in protecting the unintegrated 3' processed linear HIV-1 cDNA from exonucleolytic degradation. PMID: 28914817
- mono-specific anti-DFS70 antibodies are a strong discriminator between ANA positive healthy controls and patients with systemic autoimmune rheumatic diseases. PMID: 28770702
- Authors report here that the endogenous levels of LEDGF/p75 are upregulated in metastatic castration resistant prostate cancer (mCRPC) cells selected for resistance to the taxane drug docetaxel (DTX). PMID: 28212536
- An important role of PSIP1 in triple negative breast cancer tumorigenicity by promoting the expression of genes that control the cell cycle and tumor metastasis PMID: 28633434
- We identify the Myc-interacting protein JPO2 and its partner binding protein LEDGF/p75 as critical modulators of PI3K/AKT signaling and metastasis in medulloblastoma PMID: 27013196
- The association of LEDGF proteins with the FACT complex and give further support to a role of SSRP1 in HIV-1 infection. PMID: 27216501
- short isoform (p52) of a transcriptional co-activator-PC4 and SF2 interacting protein (Psip1), which is known to be involved in linking transcription to RNA processing, specifically regulates the expression of the lncRNA Hottip-located at the 5' end of the Hoxa locus PMID: 28384324
- Germline polymorphisms in an enhancer of PSIP1 are associated with epithelial ovarian cancer. PMID: 26840454
- PSIP1 likely plays an important role in Hereditary Hearing Loss. PMID: 26689366
- LEDGF/p75 Overexpression Attenuates Oxidative Stress-Induced Necrosis and Upregulates the Oxidoreductase ERP57/PDIA3/GRP58 in Prostate Cancer PMID: 26771192
- common LEDGF/p75 interaction interface shared by JPO2, PogZ, MLL1, IWS1 and HIV IN PMID: 26245978
- Results show that these antibodies are highly specific for dense fine speckles 70 protein DFS70/LEDGFp75 and do not target methyl CpG binding protein 2 (MeCP2). PMID: 26235378
- LEDGF/p75 interacts with splicing factors, contributes to exon choice, and directs HIV-1 integration to transcription units that are highly spliced. PMID: 26545813
- Together, these results provide evidence for an Integrase/Pol mediated uptake of LEDGF/p75 in HIV-1 viral particles and a specific cleavage by HIV protease. PMID: 25809198
- Altogether, these results indicate that a complex containing LEDGF/p75, Iws1, and Spt6 participates in regulating postintegration steps of HIV latency. PMID: 25590759
- LEDGF and 44 other novel putative nuclear targets of human thioredoxin 1 have been identified. PMID: 25231459
- Results of the present work reinforce the association of PSIP1 gene and rs61744944 single nucleotide polymorphism with HIV-1 infection long-term nonprogressors status. PMID: 25047784
- Data show that the same site on integrase-binding domain (IBD) of lens epithelium-derived growth factor (LEDGF) is involved in binding to MLL protein and HIV-IN (integrase), indicating an approach to target LEDGF in both leukemia and HIV infection. PMID: 25305204
- Authors identified an additional LEDGF/p75-MLL interface, which overlaps with the binding site of known LEDGF/p75 interactors-HIV-1 integrase, PogZ, and JPO2. PMID: 25082813
- a regulation of LEDGF interaction with chromatin by cellular partners of its PWWP domain could be involved in several processes linked to LEDGF tethering properties, such as lentiviral integration, DNA repair or transcriptional regulation PMID: 24312278
- LEDGF is crucial for the growth and survival of HPV-positive cancer cells PMID: 24604027
- Data indicate that JPO2 and LEDGF/p75 interact directly and specifically in vivo through the specific interaction domain of JPO2 and the C-terminal domain of LEDGF/p75. PMID: 24634210
- conclude that FBXO10, a candidate breast cancer susceptibility associated gene, is induced by cellular stress and LEDGF may play a role in expression of this gene PMID: 23138933
- Data indicate that the stabilized peptides inhibit the interaction of HIV-1 integrase (IN) with the cellular cofactor LEDGF/p75. PMID: 23758584
- LEDGF organizes and stabilizes an active integrase tetramer suitable for specific viral DNA integration. PMID: 23593299
- Although identified in a cohort of long-term nonprogressors, our study did not indicate that the I436S or T473I mutation in LEDGF/p75 affects the interaction with HIV-1 integrase. PMID: 23211777
- Collectively, results reveal the involvement of LEDGF-mediated elevated expression of Hsp27-dependent survival pathway(s) in prostate cancer PMID: 22647853
- The observed variation in LEDGF/p75 expression was not correlated with the disease progression. PMID: 23226247
- A role for the human immunodeficiency virus type 1 capsid CA protein in determining the dependency of HIV-1 on LEDGF/p75 during infection highlights a connection between the viral capsid and chromosomal DNA integration. PMID: 23097450
- Cotransfection studies with Sp1 in Drosophila cells that were Sp1-deficient, showed increased LEDGF/p75 transcription. PMID: 22615874
- reduced LEDGF/p75 levels may play a role in resistance to HIV-1 infection. PMID: 22479480
- findings provide insights into the regulation and regulatory functions of LEDGF in Sumoylation-dependent transcriptional control that may be essential for modifying the physiology of cells to maintain cellular homeostasis PMID: 22748127
- Depletion of LEDGF impairs the recruitment of C-terminal binding protein interacting protein (CtIP) to DNA DSBs and the subsequent CtIP-dependent DNA-end resection. PMID: 22773103
- We propose that Psip1/p52, through its binding to both chromatin and splicing factors, might act to modulate splicing PMID: 22615581
- The LEDGF/p75-MeCP2 interaction differentially influences Hsp27pr activation depending on the cellular and molecular context. PMID: 22275515
- findings suggest that genetic variation in LEDGF may influence susceptibility to HIV-1 infection and disease progression, which provides in-vivo evidence that LEDGF/p75 is an important host cofactor for HIV-1 replication PMID: 22317832
- Results further establish LEDGF/p75 as a cancer-related protein, and provide a rationale for ongoing studies aimed at understanding the clinical significance of its expression in specific human cancers. PMID: 22276150
- The fusion genes combining NUP98 exon 11/12 with PSIP1 exon 8 may be implicated in the pathogenesis of myelodysplastic syndrome (MDS). PMID: 22103895
- P23H rhodopsin as well as WT rhodopsin form aggregates in RPE cells and LEDGF(1-326) decreases these aggregates. Further, LEDGF(1-326) reduces the RPE cell damage caused by P23H rhodopsin. PMID: 21915354
- Computational, biochemical, and genetic approaches enabled us to identify the transcription factor Sp1 as a key modulator of the PSIP1 promoter, controlling LEDGF/p75 transcription through two binding sites PMID: 22019592
- LEDGF/DFS70 activates the MK2/IL6/STAT3 pathway in HaCaT keratinocytes. PMID: 21676593
- We conclude that serum IgE-anti-DFS70 autoantibodies (aAbs) and IgG(4)-anti-DFS70 aAbs may be related to the severity of atopic dermatitis. PMID: 21329475
- Association of polymorphisms in the LEDGF/p75 gene (PSIP1) with susceptibility to HIV-1 infection and disease progression may affect patients outcomes. PMID: 21681054
- We confirm that p75 is useful in differentiating atypical fibroxanthoma from spindle cell melanoma. PMID: 21623867
- The memory subset of CD4+ T cells showed significantly higher expression levels of APOBEC3G, TRIM5alpha, and LEDGF/p75. PMID: 21784078
- The effect of HIV-1 integrase on the chromatin binding of LEDGF/p75 requires the direct interaction of these two proteins. PMID: 21510906
- LEDGF dominant interference and depletion impair HIV-1 integration at distinct postentry stages. PMID: 21270171
- ectopic expression of LEDGF/DFS70 in keratinocytes could be involved in the pathology of psoriasis vulgaris PMID: 20631726
- It appears that the lack of integration observed in HIV-1 infected LEDGF/p75-knockdown cells is due mainly to the inhibitory effect of Rev following the formation of a Rev-integrase complex. PMID: 20678206
顯示更多
收起更多
-
相關疾病:A chromosomal aberration involving PSIP1 is associated with pediatric acute myeloid leukemia (AML) with intermediate characteristics between M2-M3 French-American-British (FAB) subtypes. Translocation t(9;11)(p22;p15) with NUP98. The chimeric transcript is an in-frame fusion of NUP98 exon 8 to PSIP1 exon 4.
-
亞細胞定位:Nucleus. Note=Remains chromatin-associated throughout the cell cycle.
-
蛋白家族:HDGF family
-
組織特異性:Widely expressed. Expressed at high level in the thymus. Expressed in fetal and adult brain. Expressed in neurons, but not astrocytes. Markedly elevated in fetal as compared to adult brain. In the adult brain, expressed in the subventricular zone (SVZ), i
-
數據庫鏈接:
Most popular with customers
-
-
YWHAB Recombinant Monoclonal Antibody
Applications: ELISA, WB, IHC, IF, FC
Species Reactivity: Human, Mouse, Rat
-
Phospho-YAP1 (S127) Recombinant Monoclonal Antibody
Applications: ELISA, WB, IHC
Species Reactivity: Human
-
-
-
-
-